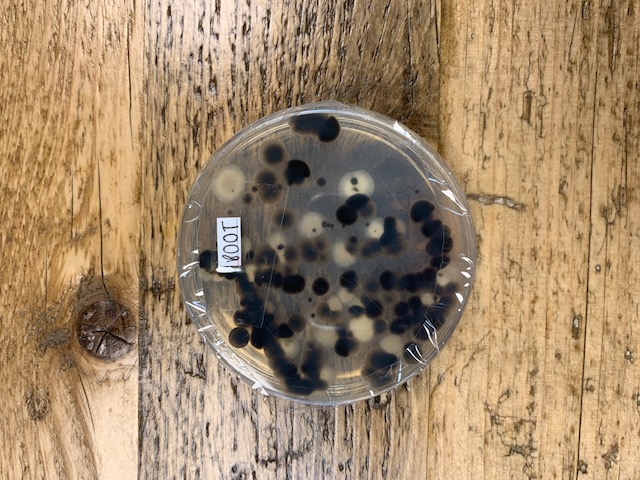
Day 5 Boot Germs

How dirty is your car?
Have you ever got into a friend’s car and found your feet surrounded by food wrappers? Found a particularly fluffy piece of food under your driver’s seat? How many times have you seen “CLEAN ME” written on a less-white-than-it-used-to-be van?
We’re often asked whether the UK is a nation of good drivers, but is it a nation of clean cars? According to recent data – the answer seems to be less than encouraging. Whether it’s flooded footwells, crusty cupholders or less-than-perfect paint jobs, we’ve put our driving cleanliness to the test to find the dirtiest secrets of the UK’s cars.

Millennial munchers & stingy spenders
When thinking about what makes dirty cars, the first thing that springs to mind is food and drink waste. Our survey data revealed that 15% of us eat and drink in our cars every single day. Millennials are the biggest culprits for eating on the move, with almost half (46%) admitting to snacking regularly while behind the wheel.
In fact, a quarter of UK adults (25%) admitted they would even retrieve and eat food, such as crisps or sandwiches, that they had dropped in to the footwell of their vehicle, if they appeared to be clean – something our experiment findings may make you think twice about doing in future.
Of course, not everyone is so keen. Over a quarter of us (27%) will try not to eat or drink while driving, with one in ten (10%) flat out refusing to entertain any food or liquid in their cars whatsoever.
As for cleaning our vehicles, the majority of us either forget, can’t be bothered or simply don’t want to spend the money on keeping things tidy. While just over a third of drivers commit to cleaning both the inside (35%) and outside (37%) of their cars thoroughly every couple of months, 61% of respondents stated they spend a grand total of £0 per month on cleaning their vehicles, with only 22% willing to spend up to a tenner on doing so.
For the motorway mealtime enthusiasts among us, it’s worth remembering that eating while driving can get you into trouble with the law. In our drivers’ confessions blog, we mentioned being distracted at the wheel can potentially land you with a £100 fine and three to nine points on your licence. So next time the drive-thru is calling, you might want to wait to get home before tucking in.

Where is the grimiest place in your car?
To delve deeper into the world of car cleanliness, we carried out an experiment to establish where the dirtiest parts of our cars are. Working on a test vehicle used for commuting and social purposes (and driven by a dog owner), our researchers took 12 swabs from different areas of the car.
Areas tested included everywhere from seatbelt clips to stereo buttons. Once taken, the swabs were placed in petri dishes and observed over a five-day period. Unsurprisingly, all areas tested showed signs of germs and bacteria, however the top five dirtiest areas were:
- Driver footwell
- Boot
- Cup holder
- Front passenger footwell
- Passenger seat

Even though activities like eating and chauffeuring young children and pets play a big part in dictating the cleanliness of our vehicles, it appears that the most commonly used areas of the car still come out as the dirtiest, rather than the areas that are more associated with litter and waste from our in-car habits.
Five tips for cleaning your car
If the above has scared you enough to take some action, here are five tips for keeping your car spick and span.
- Little and often: Regular efforts to clean your vehicle will take a lot less time and effort, plus they’ll keep your car clean more of the time. Millennial drivers buy into this idea the most, with 18.4% claiming to do some cleaning every day.
- Time it right: Hot, sunny days are typically thought of as the most suitable to get the hose and sponge out but be careful with how much you’re doing. While a rinse and a shampoo are fine, waxing and using other treatments on your car in the heat can actually do more bad than good (wax, for example, could damage your paintwork), so make sure to pick your moment.
- Work methodically: It’s best to get the inside or your car done before anything on the outside gets wet, and then start from the top and work down when washing the outside – using gravity to your advantage.
- Smaller details: Since we’re talking about germs, make sure to pay attention to the smaller details and some of the potentially germier areas of your car. Clean the steering wheel, disinfect the cup holder and wipe down the door handles and in-car controls to keep things sanitary.
- A cleaner you is a cleaner car: Keeping handy little helpers such as anti-bacterial gel and wet wipes in your vehicle will promote better habits such as ensuring your hands are clean before you snack or after you’ve eaten, meaning you’re less likely to be spreading germs around to the various surfaces you touch within your car.
Dr Asif Munaf, medical doctor and founder of wellness company, Endorance, highlighted the importance of cleaning our vehicles regularly, and explained more about the adverse effects we could suffer from dirty cars:
"The effects of not cleaning your car regularly can range from worsening of dust allergy and allergic rhinitis all the way to skin infections and worsening of asthma. There can be eye and sinus infections as well as chest infections especially when the radiator is not cleaned."
The UK’s dirtiest driver revealed
Following our research, we wanted to find the dirtiest cars out there, and so we launched a competition asking for UK drivers to share pictures of the most dirty cars (whether it was their own or the car of a friend or relative) with us via Twitter.
We had plenty of dirty cars in our competition, 53 to be precise, and it was tough to crown a winner, but in the end, we managed to pick one – and we’re sure you’ll agree it’s a well deserving prize-winner. Congratulations to @Lindsey855, we hope you enjoy your prize!.
